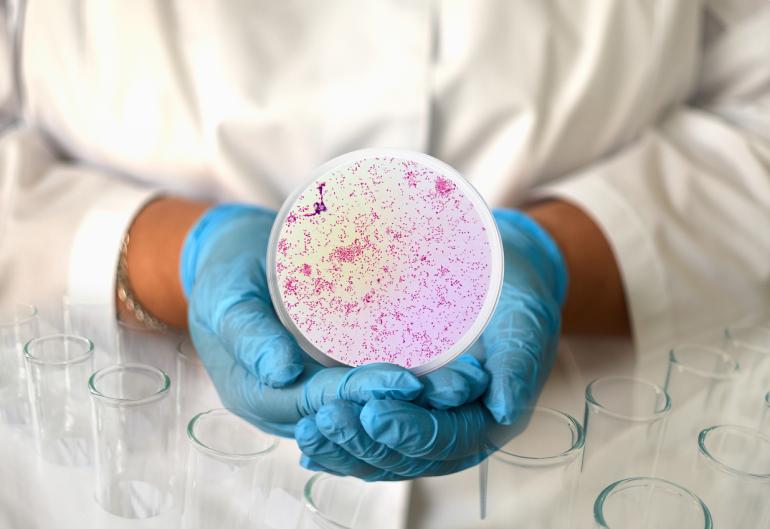

Hrozí pandemie superkapavky? I nadužívání antibiotik při covidu zhoršuje situaci.
Odborníky však neznepokojuje pouze celkový nárůst výskytu nebezpečné infekce. Bakterie Neisseria gonorrhoeae, která kapavku způsobuje, navíc mutuje. „Existují kmeny, které v průběhu let zmutovaly – získaly odolnost na běžná antibiotika. Tato nemoc je pak rezistentní vůči ceftriaxonu a azithromycinu – dvěma lékům, které Světová zdravotnická organizace doporučuje pacientům s kapavkou,“ vysvětluje MUDr. Marek Broul, urolog a sexuolog z Masarykovy nemocnice v Ústí nad Labem.
Právě azithromycin se používá nejen k léčbě kapavky, ale také jako přípravek proti infekcím dýchacích cest nebo nosních dutin. Během posledního roku byl navíc masivně využívaný u hospitalizovaných pacientů s COVID-19 jako antibiotická léčba sekundárních infekcí. Často však zbytečně, jak ukázala například studie v amerických nemocnicích. Podle ní pouze pětina pacientů, kteří dostávali antibiotika, skutečně měla bakteriální infekci plic, která takovou léčbu vyžadovala.
Nadužívání podle WHO vede k tomu, že se tato antibiotika stávají v boji proti kapavce neúčinnými. Vzniká tak superkapavka, která dokonce může být podle některých odhadů zcela neléčitelná v současnosti dostupnými preparáty. To může, kromě bolestivě probíhající infekce s nepříjemným výtokem, vést k dlouhodobým drastickým komplikacím. Mezi ně patří neplodnost, případně ohrožení plodu infekcí, pokud dojde k otěhotnění.
Plánujete „Léto lásky“?
Zmíněné obavy britských lékařů vycházejí z předpokladu, že uvolnění pandemických restrikcí bude znamenat jednoduše více náhodného sexu. Vzpomeňme na „zlatá dvacátá léta“, kdy odeznění pandemie španělské chřipky nastartovalo společenský život a sexuální revoluci. Čeká nás tedy léto nespoutaného sexu?
Podle MUDr. Marka Broula je to zcela individuální: „Extroverti, kterým bohatý sociální život v době pandemie chyběl, jistě rádi do společnosti vyrazí a užijí si ho včetně možnosti nahodilého sexu. Naopak introverti, kteří poznali, že jim domácí izolace vlastně vyhovuje, budou nadále zavřeni doma a žádná dobrodružství vyhledávat nebudou.“ Pokud navíc patříte mezi nezadané, je možné, že vás lákají nová dobrodružství. Podle studie Láska a sex za časů koronaviru totiž singles nesli měsíce omezení mnohem hůř než zadaní.
Prevence, která nesnižuje rozkoš
Ať budete mít sex s novými partnery náhodně, či plánovaně, myslete na ochranu svého zdraví. „Především je třeba si uvědomit, zda nahodilý sex opravdu chci. Pokud se již rozhodnu, poté si partnera raději vybrat pořádně a nikdy nezapomenout na kondom,“ vybízí MUDr. Marek Broul.
Kondom totiž vytváří bariéru, přes kterou s 98% spolehlivostí neproniknou sekrety pohlavních orgánů, které mohou obsahovat kapavkové bakterie. Navíc je vhodné motivovat k jeho používání také náctileté potomky. Studenti se totiž k volnému sexu staví velmi pozitivně, jak vyplynulo z průzkumu provedeného na University of Washington. 73 % studentů v něm uvedlo, že v následujících měsících s útlumem pandemie očekávají více nahodilého sexu.
Nemusí přitom jít o poučování. „Pojměte nabídku kondomů svým teenagerům jako dobrý tip, jak se ochránit a zároveň si sex opravdu užít. Řada lidí se jejich používání vyhýbá z důvodu obavy ze snížené rozkoše. Je to pochopitelné, protože některé jsou vyrobeny ze silnějších materiálů, které snižují pocit bezprostředního dotyku. Dnes jsou však k dispozici také ultratenké kondomy, s nimiž je milování téměř stejně příjemné, jako bez ochrany,“ radí Vojtěch Sláma, zakladatel online sexshopu Yoo.cz.
Pozor na orální sex
Vaginální nebo anální penetrace však není jediným způsobem přenosu kapavkové infekce. Je možné se nakazit také orálním sexem. Zcela logicky může bakterie přejít z genitálu také do úst a hrdla, kde způsobí bolesti v krku. Ty jsou pak snadno zaměnitelné za nachlazení. Bakterie usídlené v zadní části krku jsou také hůře léčitelné, protože se zde mísí s dalšími mikroorganismy.
Inkubační doba kapavky činí obvykle 2 až 14 dnů. U mužů se první příznaky objevují mezi 2. a 5. dnem po nakažení, u žen mezi 4. a 7. dnem. Není to ale pravidlem a někdy může nemoc probíhat bez příznaků. Prvním infikovaným místem bývá močová trubice a děložní hrdlo. Zasažen může být také konečník, hltan a dokonce spojivky očí. Vzácně se kapavka může přenést krví do velkých kloubů a vyvolat onemocnění pohybového aparátu, srdce, duhovky, mozkových blan či kůže. Infekce kapavkou navíc výrazně zvyšuje riziko nákazy virem HIV, nejspíše z důvodu narušení povrchu sliznic.
V případě výtoku se už jedná o pokročilé stadium. Zpravidla mu předchází častější močení. „Každý pocit, že něco není v genitální oblasti v pořádku, by měl být signálem k návštěvě lékaře. Jen tak je možné provést laboratorní vyšetření a včas stanovit diagnózu a zahájit vhodnou léčbu,“ upozorňuje na závěr MUDr. Marek Broul.
MK

Komentáře